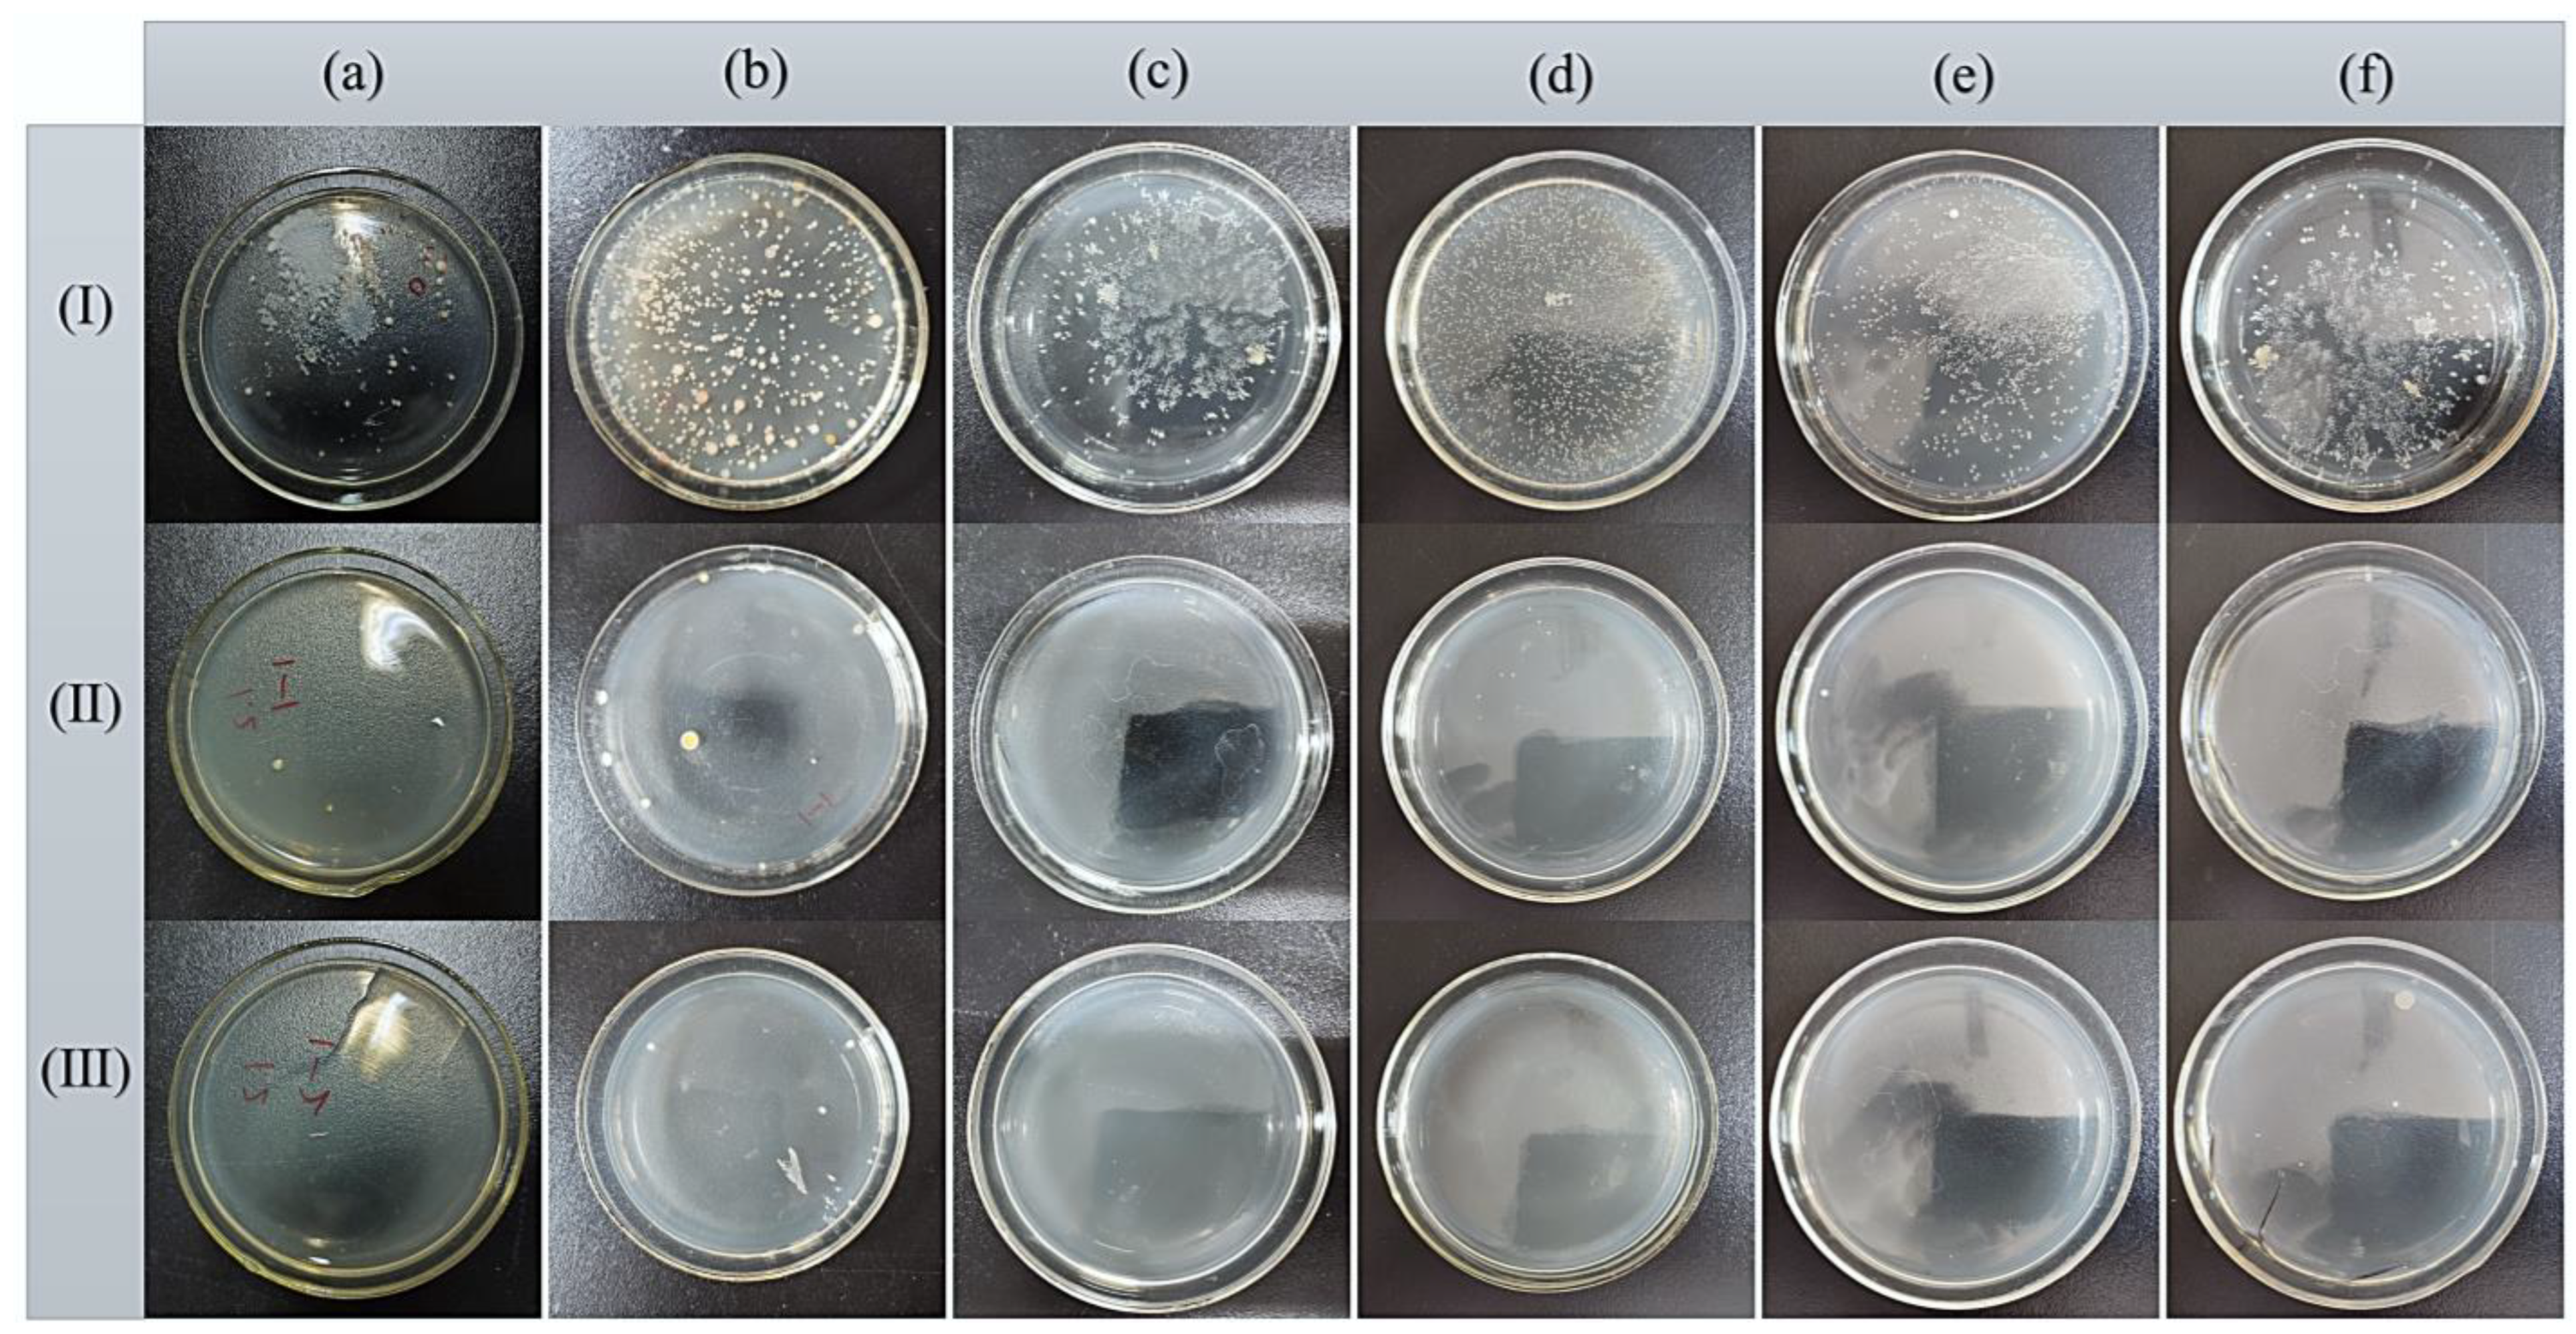
Water 16 01658 g009

Efficient H2O2 Production and Activation by Air Diffusion Cathode Combined with Ultraviolet for Lake Water Treatment: A Long-Term Evaluation
Abstract
1. Introduction
2. Materials and Methods
2.1. Materials
2.2. Preparation of CB–PTFE Air Diffusion Cathodes
2.3. Experimental Methods
2.4. Methods of Analysis
3. Results and Discussion
3.1. Performance of H2O2 Production by the Air Diffusion Cathode
3.2. Removal of Organic Pollutants and Microorganisms
3.3. Energy Consumption Analysis
4. Conclusions
Author Contributions
Funding
Data Availability Statement
Conflicts of Interest
References
- Carpenter, S.R.; Stanley, E.H.; Zanden, M.J.V. State of the World’s Freshwater Ecosystems: Physical, Chemical, and Biological Changes. Annu. Rev. Environ. Resour. 2011, 36, 75–99. [Google Scholar] [CrossRef]
- Mammides, C. A global assessment of the human pressure on the world’s lakes. Glob. Environ. Chang. 2020, 63, 102084. [Google Scholar] [CrossRef]
- Le, C.; Zha, Y.; Li, Y.; Sun, D.; Lu, H.; Yin, B. Eutrophication of lake waters in China: Cost, causes, and control. Environ. Manag. 2010, 45, 662–668. [Google Scholar] [CrossRef] [PubMed]
- Ran, J.; Xiang, R.; He, J.; Zheng, B. Spatiotemporal variation and driving factors of water quality in Yunnan-Guizhou plateau lakes, China. J. Contam. Hydrol. 2023, 254, 104141. [Google Scholar] [CrossRef] [PubMed]
- Ho, L.T.; Goethals, P.L.M. Opportunities and Challenges for the Sustainability of Lakes and Reservoirs in Relation to the Sustainable Development Goals (SDGs). Water 2019, 11, 1462. [Google Scholar] [CrossRef]
- Meffe, R.; de Bustamante, I. Emerging organic contaminants in surface water and groundwater: A first overview of the situation in Italy. Sci. Total Environ. 2014, 481, 280–295. [Google Scholar] [CrossRef] [PubMed]
- Rodil, R.; Quintana, J.B.; Concha-Graña, E.; López-Mahía, P.; Muniategui-Lorenzo, S.; Prada-Rodríguez, D. Emerging pollutants in sewage, surface and drinking water in Galicia (NW Spain). Chemosphere 2012, 86, 1040–1049. [Google Scholar] [CrossRef] [PubMed]
- Bui, X.T.; Vo, T.P.T.; Ngo, H.H.; Guo, W.S.; Nguyen, T.T. Multicriteria assessment of advanced treatment technologies for micropollutants removal at large-scale applications. Sci. Total Environ. 2016, 563–564, 1050–1067. [Google Scholar] [CrossRef]
- Chu, W.-H.; Gao, N.-Y.; Templeton, M.R.; Yin, D.-Q. Comparison of inclined plate sedimentation and dissolved air flotation for the minimisation of subsequent nitrogenous disinfection by-product formation. Chemosphere 2011, 83, 647–651. [Google Scholar] [CrossRef]
- Jia, P.; Zhou, Y.; Zhang, X.; Zhang, Y.; Dai, R. Cyanobacterium removal and control of algal organic matter (AOM) release by UV/H2O2 pre-oxidation enhanced Fe(II) coagulation. Water Res. 2018, 131, 122–130. [Google Scholar] [CrossRef]
- Rodriguez-Narvaez, O.M.; Peralta-Hernandez, J.M.; Goonetilleke, A.; Bandala, E.R. Treatment technologies for emerging contaminants in water: A review. Chem. Eng. J. 2017, 323, 361–380. [Google Scholar] [CrossRef]
- Zhu, Y.; Wu, M.; Gao, N.; Chu, W.; Li, K.; Chen, S. Degradation of phenacetin by the UV/chlorine advanced oxidation process: Kinetics, pathways, and toxicity evaluation. Chem. Eng. J. 2018, 335, 520–529. [Google Scholar] [CrossRef]
- Lee, M.; Merle, T.; Rentsch, D.; Canonica, S.; von Gunten, U. Abatement of Polychoro-1,3-butadienes in Aqueous Solution by Ozone, UV Photolysis, and Advanced Oxidation Processes (O3/H2O2 and UV/H2O2). Environ. Sci. Technol. 2017, 51, 497–505. [Google Scholar] [CrossRef] [PubMed]
- Yang, Y.; Pignatello, J.J.; Ma, J.; Mitch, W.A. Effect of matrix components on UV/H2O2 and UV/S2O82− advanced oxidation processes for trace organic degradation in reverse osmosis brines from municipal wastewater reuse facilities. Water Res. 2016, 89, 192–200. [Google Scholar] [CrossRef] [PubMed]
- Rozas, O.; Vidal, C.; Baeza, C.; Jardim, W.F.; Rossner, A.; Mansilla, H.D. Organic micropollutants (OMPs) in natural waters: Oxidation by UV/H2O2 treatment and toxicity assessment. Water Res. 2016, 98, 109–118. [Google Scholar] [CrossRef] [PubMed]
- Ali, M.A.; Maafa, I.M.; Qudsieh, I.Y. Photodegradation of Methylene Blue Using a UV/H2O2 Irradiation System. Water 2024, 16, 453. [Google Scholar] [CrossRef]
- Song, W.; Li, C.; Du, Z.; Yue, J.; Sun, W.; Hou, L.; Liu, J.; Jia, R. Research about Organic Matter Removal and Biofilms Development of Pilot-Scale UV/H2O2-BAC Process. Water 2021, 13, 565. [Google Scholar] [CrossRef]
- Zhou, W.; Meng, X.; Gao, J.; Alshawabkeh, A.N. Hydrogen peroxide generation from O2 electroreduction for environmental remediation: A state-of-the-art review. Chemosphere 2019, 225, 588–607. [Google Scholar] [CrossRef] [PubMed]
- Salmerón, I.; Plakas, K.V.; Oller, I.S.I.; Maldonado, M.I.; Karabelas, A.J.; Malato, S. Optimization of electrocatalytic H2O2 production at pilot plant scale for solar-assisted water treatment. Appl. Catal. B Environ. Energy 2019, 242, 327–336. [Google Scholar] [CrossRef]
- Wang, Y.; Yu, G.; Deng, S.; Huang, J.; Wang, B. The electro-peroxone process for the abatement of emerging contaminants: Mechanisms, recent advances, and prospects. Chemosphere 2018, 208, 640–654. [Google Scholar] [CrossRef]
- Zhao, Y.; Deng, N.; Fan, Z.; Hu, Z.; Fan, L.; Zhou, J.; Huang, X. On-site H2O2 electro-generation process combined with ultraviolet: A promising approach for odorous compounds purification in drinking water system. Chem. Eng. J. 2022, 430, 132829. [Google Scholar] [CrossRef]
- Li, Y.; Zhang, Y.; Xia, G.; Zhan, J.; Yu, G.; Wang, Y. Evaluation of the technoeconomic feasibility of electrochemical hydrogen peroxide production for decentralized water treatment. Front. Environ. Sci. Eng. 2020, 15, 122417–122851. [Google Scholar] [CrossRef]
- Ma, Y.; Zhao, E.; Xia, G.; Zhan, J.; Yu, G.; Wang, Y. Effects of water constituents on the stability of gas diffusion electrode during electrochemical hydrogen peroxide production for water and wastewater treatment. Water Res. 2023, 229, 119503. [Google Scholar] [CrossRef] [PubMed]
- Liao, P.; Yuan, S.; Chen, M.; Tong, M.; Xie, W.; Zhang, P. Regulation of electrochemically generated ferrous ions from an iron cathode for Pd-catalytic transformation of MTBE in groundwater. Environ. Sci. Technol. 2013, 47, 7918–7926. [Google Scholar] [CrossRef] [PubMed]
- Li, L.; Li, Y.; Liang, J.; Zhao, Z. Elimination method of H2O2 interference in determination of CODCr. Exp. Technol. Manag. 2021, 38, 47–53+60. (In Chinese) [Google Scholar] [CrossRef]
- Liu, Y.; Quan, X.; Fan, X.; Wang, H.; Chen, S. High-yield electrosynthesis of hydrogen peroxide from oxygen reduction by hierarchically porous carbon. Angew. Chem. 2015, 54, 6837–6841. [Google Scholar] [CrossRef]
- Zhang, Q.; Zhou, M.; Ren, G.; Li, Y.; Li, Y.; Du, X. Highly efficient electrosynthesis of hydrogen peroxide on a superhydrophobic three-phase interface by natural air diffusion. Nat. Commun. 2020, 11, 1731. [Google Scholar] [CrossRef] [PubMed]
- Jin, Q.; Wang, H.; Hu, C.; Chen, Z.; Wang, X. Effects of NOM on the degradation of chloramphenicol by UV/H2O2 and the characteristics of degradation products. Sep. Purif. Technol. 2018, 191, 108–115. [Google Scholar] [CrossRef]
- Sarathya, S.R.; Stefan, M.I.; Royce, A.; Mohseni, M. Pilot-scale UV/H2O2 advanced oxidation process for surface water treatment and downstream biological treatment: Effects on natural organic matter characteristics and DBP formation potential. Environ. Technol. 2011, 33, 1709–1718. [Google Scholar] [CrossRef]
- Wang, Y.; Li, G.; Song, W.; Sun, S.; Zhang, S.; Li, M.; Jia, R. Removal Characteristics of Organic Matter in Effluent from Conventional Sand Filtration by UV/H2O2 Process. China Water Wastewater 2022, 38, 60–66. (In Chinese) [Google Scholar] [CrossRef]
- García-Morales, M.A.; Roa-Morales, G.; Barrera-Díaz, C.; Miranda, V.M.; Hernández, P.B.; Silva, T.B.P. Integrated Advanced Oxidation Process (Ozonation) and Electrocoagulation Treatments for Dye Removal in Denim Effluents. Int. J. Electrochem. Sci. 2013, 8, 8752–8763. [Google Scholar] [CrossRef]
- Valencia, S.; Marín, J.; Velásquez, J.; Restrepo, G.; Frimmel, F.H. Study of pH effects on the evolution of properties of brown-water natural organic matter as revealed by size-exclusion chromatography during photocatalytic degradation. Water Res. 2011, 46, 1198–1206. [Google Scholar] [CrossRef] [PubMed]
- Świetlik, J.; Sikorska, E. Application of fluorescence spectroscopy in the studies of natural organic matter fractions reactivity with chlorine dioxide and ozone. Water Res. 2004, 38, 3791–3799. [Google Scholar] [CrossRef]
- Valencia, S.; Marín, J.M.; Restrepo, G.; Frimmel, F.H. Evaluation of natural organic matter changes from Lake Hohloh by three-dimensional excitation–emission matrix fluorescence spectroscopy during TiO2/UV process. Water Res. 2014, 51, 124–133. [Google Scholar] [CrossRef] [PubMed]
- Guo, K.; Wu, Z.; Yan, S.; Yao, B.; Song, W.; Hua, Z.; Zhang, X.; Kong, X.; Li, X.; Fang, J. Comparison of the UV/chlorine and UV/H2O2 processes in the degradation of PPCPs in simulated drinking water and wastewater: Kinetics, radical mechanism and energy requirements. Water Res. 2018, 147, 184–194. [Google Scholar] [CrossRef]
- Miklos, D.B.; Remy, C.; Jekel, M.; Linden, K.G.; Drewes, J.E.; Hübner, U. Evaluation of advanced oxidation processes for water and wastewater treatment—A critical review. Water Res. 2018, 139, 118–131. [Google Scholar] [CrossRef]

| Parameters | Cl− | SO42− | Ca2+ | Mg2+ | COD | TOC |
|---|---|---|---|---|---|---|
| Concentration (mg·L−1) | 38.9 ± 0.99 | 63.4 ± 1.12 | 40.8 ± 0.82 | 7.6 ± 0.15 | 37.0 ± 5.21 | 7.35 ± 1.36 |
| Reaction Time | H2O2 (mg·L−1) | COD (mg·L−1) | A254 |
|---|---|---|---|
| 0 h | 63.93 ± 2.20 | 42 ± 2.83 | 0.104 ± 0.001 |
| 1 h | 62.20 ± 0.73 | 41 ± 4.24 | 0.097 ± 0.001 |
Disclaimer/Publisher’s Note: The statements, opinions and data contained in all publications are solely those of the individual author(s) and contributor(s) and not of MDPI and/or the editor(s). MDPI and/or the editor(s) disclaim responsibility for any injury to people or property resulting from any ideas, methods, instructions or products referred to in the content. |
© 2024 by the authors. Licensee MDPI, Basel, Switzerland. This article is an open access article distributed under the terms and conditions of the Creative Commons Attribution (CC BY) license (https://creativecommons.org/licenses/by/4.0/).
Share and Cite
Hong, H.; Xie, S.; Qiu, A.; Yao, Y.; Jiang, W.; Li, J.; Wan, Z.; Xiang, S.; Xi, C.; Xiao, J.; et al. Efficient H2O2 Production and Activation by Air Diffusion Cathode Combined with Ultraviolet for Lake Water Treatment: A Long-Term Evaluation. Water 2024, 16, 1658. https://doi.org/10.3390/w16121658
Hong H, Xie S, Qiu A, Yao Y, Jiang W, Li J, Wan Z, Xiang S, Xi C, Xiao J, et al. Efficient H2O2 Production and Activation by Air Diffusion Cathode Combined with Ultraviolet for Lake Water Treatment: A Long-Term Evaluation. Water. 2024; 16(12):1658. https://doi.org/10.3390/w16121658
Chicago/Turabian StyleHong, Hui, Shiwei Xie, Aoxue Qiu, Yuming Yao, Wenzhe Jiang, Jilei Li, Zihao Wan, Shengjie Xiang, Chenyi Xi, Jingxian Xiao, and et al. 2024. "Efficient H2O2 Production and Activation by Air Diffusion Cathode Combined with Ultraviolet for Lake Water Treatment: A Long-Term Evaluation" Water 16, no. 12: 1658. https://doi.org/10.3390/w16121658
APA StyleHong, H., Xie, S., Qiu, A., Yao, Y., Jiang, W., Li, J., Wan, Z., Xiang, S., Xi, C., Xiao, J., & Zhang, N. (2024). Efficient H2O2 Production and Activation by Air Diffusion Cathode Combined with Ultraviolet for Lake Water Treatment: A Long-Term Evaluation. Water, 16(12), 1658. https://doi.org/10.3390/w16121658






